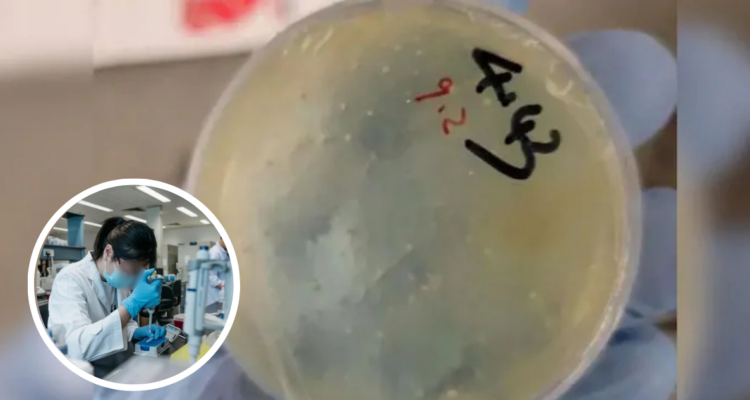
Científica china en EEUU

Medios en Estados Unidos confirmaron la detención de una científica china acusada de supuesto contrabando de material biológico. El arresto se dio en el aeropuerto de Detroit, mientras que la mujer era originaria de Wuhan.
Chengxuan Han, quien cursaba un doctorado en la Huazhong University of Science and Technology, también fue acusada de, presuntamente, haber mentido a las autoridades.
A través de un comunicado del Departamento de Justicia, el fiscal Jerome F. Gorgon indicó que la profesional tenía planeado estudiar una temporada en la Universidad Metropolitana de Detroit.
Asimismo, entre 2024 y 2025 habría enviado hasta cuatro paquetes con material biológico, desde China a Estados Unidos, los cuales habrían sido dirigidos a laboratorios de la mencionada casa de estudios.
Junto con eso, en el control del aeropuerto se detectó que ella había eliminado información de su teléfono celular, además de haber mentido respecto a los paquetes antes mencionados.
Caso de científica china en EEUU
El fiscal aseguró que, luego de varios interrogatorios, la involucrada reconoció que el material biológico enviado tenía relación con lombrices (nematodos), para posterior estudio.
“El presunto contrabando de materiales biológicos por parte de esta extranjera proveniente de una universidad de ciencia y tecnología en Wuhan, China, con destino a un laboratorio de la Universidad de Míchigan, forma parte de un patrón alarmante que amenaza nuestra seguridad”, expuso Gorgon.
Durante la semana pasada, en Estados Unidos se había acusado a otros dos científicos chinos por supuesto contrabando de un hongo tóxico a la misma universidad en Detroit.
Uno de ellos fue deportado hasta su país de origen, mientras que el segundo se encuentra en prisión a la espera de que finalice la investigación.
El caso de Chengxuan Han podría ser igual de complejo. Desde Estados Unidos confirmaron que quedó bajo custodia policial.







 Enviando corrección, espere un momento...
Enviando corrección, espere un momento...